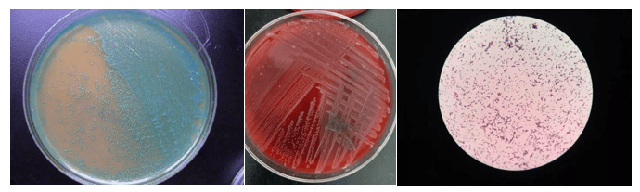

Một phụ nữ mang thai ở Thâm Quyến (Trung Quốc) đã bị sảy thai chỉ sau 17 giờ nhập viện với tình trạng sốt cao và nhiễm khuẩn nặng. Nguyên nhân đau lòng được xác định là do nhiễm khuẩn Listeria monocytogenes - một loại vi khuẩn cực kỳ nguy hiểm có thể tồn tại trong tủ lạnh.
Nhập viện trong tình trạng cấp bách và diễn biến nhanh chóng
Mới đây, tài khoản WeChat của Bệnh viện Nhân dân Thứ ba Thâm Quyến đã đăng tải một trường hợp đặc biệt: Xiao Chen (tên đã được thay đổi để bảo vệ danh tính), một thai phụ 30 tuổi ở Thâm Quyến, mang thai được 26 tuần và bước vào giai đoạn giữa của thai kỳ thì bất ngờ tai họa đã ập xuống mà không hề có dấu hiệu báo trước.

Bệnh viện đã tiếp nhận Xiao Chen vào một buổi sáng sớm khi cô đang ở giữa thai kỳ và được đưa đến bệnh viện trong tình trạng sốt liên tục. Xiao Chen nhập viện với tình trạng rất khẩn cấp, sốt cao đến 39 độ C, nhịp tim thai nhi rất nhanh và đã xuất hiện co thắt tử cung không điều hòa. Điều này có nghĩa là cô có thể sẽ đối mặt với các tình huống nguy hiểm như sảy thai, thai chết lưu, dị tật bẩm sinh và tử vong sơ sinh.
Sự ra đi của thai nhi và cuộc điều tra nguyên nhân
Đội ngũ y tế sản khoa đã ngay lập tức tiến hành cứu chữa và mời các chuyên gia từ khoa nhiễm khuẩn để tham vấn, tiến hành nhiều cuộc thảo luận. Tuy nhiên, tình hình phát triển của bệnh còn nhanh hơn dự đoán - dù đã sử dụng cả loại kháng sinh cấp độ cao nhất để điều trị nhiễm khuẩn, bệnh tình vẫn không kiểm soát được và hiệu quả của thuốc hầu như không thấy.
Vào tối cùng ngày nhập viện, khoảng 7 giờ tối, Xiao Chen bắt đầu có dấu hiệu của co thắt tử cung không điều hòa cùng với tình trạng chảy máu âm đạo và nhịp tim thai nhi giảm đi liên tục.
Mặc dù đội ngũ y tế đã nỗ lực hết sức, thai nhi vẫn không may mắn đã bị sảy. Tất cả đã xảy ra chỉ trong vòng chưa đầy 17 giờ kể từ khi chị Chen nhập viện.
Phát hiện "kẻ giết người trong tủ lạnh"
Sau khi sảy thai, Xiao Chen vẫn tiếp tục sốt cao. Nguyên nhân của bệnh tình không rõ ràng khiến công việc điều trị gặp khó khăn. Đột phá xuất hiện khi kết quả xét nghiệm máu cho thấy Listeria monocytogenes dương tính - điều này giải thích hợp lý tất cả các triệu chứng lâm sàng mà Xiao Chen gặp phải. Nhóm y tế đã ngay lập tức điều chỉnh phác đồ điều trị, thay đổi kháng sinh để chống lại vi khuẩn Listeria.

Vi khuẩn Listeria monocytogenes nguy hiểm thế nào và cách phòng tránh
Listeria monocytogenes là một trong những vi khuẩn gây ra các vụ bùng phát bệnh từ thực phẩm và cũng là một trong những nguyên nhân gây tử vong do thực phẩm với tỷ lệ lên đến 20-50%. Vi khuẩn này có khả năng chịu đựng mạnh mẽ với nhiều môi trường khác nhau như nhiệt độ thấp, độ mặn cao, pH thấp và căng thẳng oxy hóa. Nhiệt độ từ 4-10 độ C là điều kiện lý tưởng để chúng phát triển mạnh mẽ, vì thế chúng còn được gọi là "kẻ giết người núp trong tủ lạnh".
Từ khi ăn phải thực phẩm chứa Listeria cho đến khi bắt đầu có triệu chứng, một số người có thể có một thời gian ủ bệnh dài, thường kéo dài đến ba tuần, thậm chí có người ủ bệnh hơn hai tháng. Thời gian ủ bệnh dài khiến việc xác định nguồn thực phẩm gây nhiễm trở nên khó khăn.
Một người lớn khỏe mạnh thực sự không cần quá lo lắng, hầu hết mọi người nhiễm Listeria không có triệu chứng, hoặc chỉ gặp các triệu chứng như tiêu chảy, sốt, đau nhức và cảm lạnh, sau vài ngày họ có thể hồi phục.
Tuy nhiên, đối với những nhóm người như phụ nữ mang thai, trẻ sơ sinh, người cao tuổi trên 65 và những người có hệ miễn dịch yếu, nhiễm Listeria có thể trở nên cực kỳ nguy hiểm. Khi hệ miễn dịch của cơ thể suy yếu, vi khuẩn Listeria có thể lây lan ra ngoài ruột và các cơ quan khác, dẫn đến các triệu chứng như đau đầu, sốt, đau cơ, cứng cổ, mơ màng, mất cân bằng và co giật.
Trong quá trình mang thai, hệ thống miễn dịch của phụ nữ sẽ thay đổi, khiến họ dễ bị nhiễm Listeria hơn. Mặc dù phụ nữ mang thai có thể chỉ gặp các triệu chứng nhẹ sau khi nhiễm, vi khuẩn có thể xâm nhập qua nhau thai và nhiễm vào thai nhi chưa sinh, gây ra sinh non hoặc sảy thai, hoặc khiến trẻ sơ sinh mắc bệnh nặng hoặc tử vong.
Các số liệu cho thấy rằng, nguy cơ phụ nữ mang thai nhiễm Listeria cao hơn người bình thường hơn 10 lần. Theo các báo cáo truyền thông trước đây, một bà bầu 37 tuần đã nhiễm Listeria từ thực phẩm lưu trữ trong tủ lạnh và cuối cùng dẫn đến thai chết lưu.

Bác sĩ Mao Xuemei, giáo sư chính của khoa phụ sản tại Bệnh viện Trung y thành phố Hàng Châu, lưu ý rằng việc tránh nhiễm Listeria không quá khó khăn, chỉ cần chú ý đến một số điểm sau:
- Duy trì vệ sinh tủ lạnh, thực hiện việc làm sạch định kỳ không chỉ có thể ngăn chặn Listeria mà còn có hiệu quả đối với việc tiêu diệt vi khuẩn Salmonella và các loại vi khuẩn khác.
- Thực phẩm sống nên được bảo quản riêng biệt, đặc biệt là thịt sống và hải sản; tránh việc rã đông nhiều lần.
- Khi bảo quản trong ngăn đá, tốt nhất là chia nhỏ thành từng phần để mỗi lần lấy ra dùng một phần.
- Nên ăn các loại thực phẩm lưu trữ trong tủ lạnh càng sớm càng tốt để tránh sự ô nhiễm chéo.
Nấu chín thực phẩm là một trong những cách quan trọng để phòng tránh vi khuẩn này. Tất cả các loại thực phẩm trước khi ăn nên được nấu chín đạt nhiệt độ thích hợp, 70 độ C nấu trong 5 phút là đủ để tiêu diệt Listeria.
Phụ nữ mang thai cũng nên tránh tiêu thụ các loại thực phẩm có nguy cơ cao như sản phẩm từ sữa chưa qua tiệt trùng, phô mai sống, kem lạnh tự chế; cũng như trái cây và rau đã được cắt sẵn, thịt và hải sản sống hoặc chưa nấu chín, trứng sống hoặc chưa chín và các loại rau sống.
Ngoài ra, việc bảo quản thực phẩm đúng cách cũng rất quan trọng, cần tuân thủ nghiêm ngặt thời gian và điều kiện bảo quản được ghi trên nhãn thực phẩm để tránh vi khuẩn phát triển quá mức. Thực phẩm không được đóng gói kín nên được bọc cẩn thận bằng túi bảo quản thực phẩm hoặc hộp trước khi cho vào tủ lạnh.



































